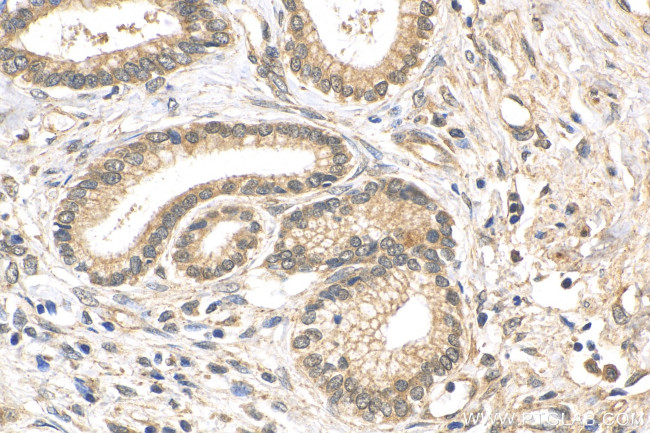
FOXM1 Antibody in Immunohistochemistry (Paraffin) (IHC (P))

Search
Proteintech
FOXM1 Polyclonal Antibody
{{$productOrderCtrl.translations['antibody.pdp.commerceCard.promotion.promotions']}}
{{$productOrderCtrl.translations['antibody.pdp.commerceCard.promotion.viewpromo']}}
{{$productOrderCtrl.translations['antibody.pdp.commerceCard.promotion.promocode']}}: {{promo.promoCode}} {{promo.promoTitle}} {{promo.promoDescription}}. {{$productOrderCtrl.translations['antibody.pdp.commerceCard.promotion.learnmore']}}
产品信息
13147-1-AP
种属反应
已发表种属
宿主/亚型
分类
类型
抗原
偶联物
形式
浓度
规格
纯化类型
保存液
内含物
保存条件
运输条件
产品详细信息
Product # 13147-1-AP is rabbit polyclonal antibody raised against C-terminal of human FOXM1. This antibody can recognize three kinds of FOXM1,FOXM1-pp (~95-110 kDa), FOXM1-B (isoform2,~83 kDa) and FOXM1A (isoform4, ~90 kDa)
Immunogen sequence: KEEEIQPGE EMPHLARPIK VESPPLEEWP SPAPSFKEES SHSWEDSSQS PTPRPKKSYS GLRSPTRCVS EMLVIQHRER RERSRSRRKQ HLLPPCVDEP ELLFSEGPST SRWAAELPFP ADSSDPASQL SYSQEVGGPF KTPIKETLPI SSTPSKSVLP RTPESWRLTP PAKVGGLDFS PVQTPQGASD PLPDPLGLMD LSTTPLQSAP PLESPQRLLS SEPLDLISVP FGNSSPSDID VPKPGSPEPQ VSGLAANRSL TEGLVLDTMN DSLSKILLDI SFPGLDEDPL GPDNINWSQF IPELQ (445-748 aa encoded by BC006192)
靶标信息
FOXM1 (forkhead box protein M1) is a transcriptional factor regulating the expression of cell cycle genes essential for DNA replication and mitosis. FOXM1 plays a role in the control of cell proliferation and DNA break repairs participating in the DNA damage checkpoint response.
仅用于科研。不用于诊断过程。未经明确授权不得转售。
生物信息学
蛋白别名: cell proliferation-inducing gene 29 protein; FKH L16; FKHL 16; forkhead box M1-D; Forkhead box protein M1; forkhead homolog 16; Forkhead like 16; Forkhead, drosophila, homolog-like 16; Forkhead-related protein FKHL16; FOXM 1; FOXM 1c; Hepatocyte nuclear factor 3 forkhead homolog 11; hepatocyte nuclear factor-3/fork head homolog 11A; winged helix transcription factor; HFH 11; HFH-11; HNF 3; HNF-3/fork-head homolog 11; HNF3; INS 1; INS1; M-phase phosphoprotein 2; MPHOSPH 2; MPM 2; MPM-2 reactive phosphoprotein 2; MPP 2; PIG 29; TGT3; Transcription factor Trident; trident; unnamed protein product; winged helix transcription factor; hepatocyte nuclear factor-3/fork head homolog 11B; Winged-helix factor from INS-1 cells; winged-helix transcription factor Trident
基因别名: AA408308; AW554517; BB238854; Fkh16; FKHL16; FOXM1; FOXM1A; FOXM1B; FOXM1C; HFH-11; HFH-11B; HFH11; HNF-3; INS-1; MPHOSPH2; Mpm2; MPP-2; MPP2; PIG29; TRIDENT; WIN
UniProt ID: (Human) Q08050
Entrez Gene ID: (Human) 2305, (Mouse) 14235